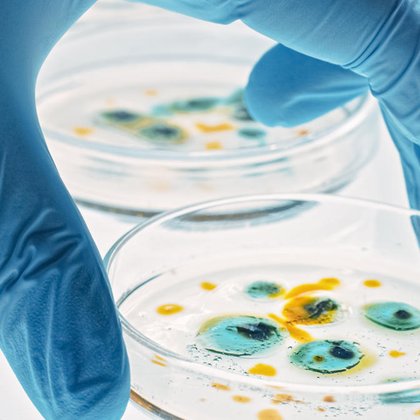
Tweet card summary image

Maïwenn Kersaudy-Kerhoas
@ClinicalMkk
Followers
1K
Following
6K
Media
266
Statuses
2K
Professor, microfluidic engineer, cofounder, @GlobalFrugalDx, contemplating or tinkering, shaking up the statu quo
Edinburgh, Scotland
Joined October 2018
🚨Preprint notice! 🚨 Our manuscript assessing material usage in commercial #lateralflow assay (LFA) kits is out in @medrxiv 📝🤩 Our goal? Set baselines for quantitative material requirements in future target product profiles for new tests. A 🧵... https://t.co/L8CwiDZDBl
#TPP
medrxiv.org
Objective To assess material usage in commercial lateral flow assay kits and determine baselines for quantitative material requirements in target product profiles for new tests. Methods We collected...
2
10
21
Global Health Workshop 2024 was a blast! Loved the engaging talks & sessions, especially the one with @GlobalFrugalDx Kudos to the organisers @debjanipaul @jac_linnes and @ClinicalMkk & speakers for putting together an incredible event! @MicroTas2025 #GlobalHealthWorkshop2025
1
2
3
Global Research Institute in Health & Care Technology @HeriotWattUni @ClinicalMkk @CMO_England @EdinburghNapier @CVHealthENU #research
0
1
4
22°C in April in #Edinburgh #Scotland... I don't think I've ever seen this in almost 20 years...😯
0
0
4
Lateral flow tests are undeniably convenient, but their environmental cost is rising. Prof Maïwenn Kersaudy-Kerhoas is calling for a limit to their plastic content in this month's @WHO bulletin. Learn more: https://t.co/sIiPnFq5AU
#HeriotWattUni
0
4
4
Hello friends and colleagues! Last few hours to submit your abstract to the CBMS Global Health virtual conference! Closing at midnight Hawai time that's 09:59 Wednesday 23rd April UTC 😁⏱️ https://t.co/Fe3otlE3eC
0
1
3
Meet our first keynote speaker at the GH Workshop 2025: Dr. Gagandeep Kang! A trailblazing scientist, now at @gatesfoundation, she’s led disruptive research on enteric diseases & vaccines in India. Catch her talk on June17 2025 👇 @ClinicalMkk @debjanipaul
https://t.co/fEqO8xvNbb
0
5
6
Delighted to say our manuscript has been published by the @WHOBulletin and will be out in their April edition!! 'Very chuffed' is an understatement!! 😍🎉 Thank you very much to Alice Street @uoessps and @maryandtheworld for the brilliant collaboration
0
0
0
Exciting times ahead! The Global Frugal Dx Network (GFDN) is thrilled to host this workshop on microfluidics & diagnostics-championing Open Hardware, Sustainability & Frugal Dx for accessible healthcare. Looking forward to insightful discussions & collaborations! #GlobalHealth
Excited for this incredible event on microfluidics & diagnostics! Great focus on Open Hardware, Sustainability & Frugal Dx—key for impactful healthcare innovation. Looking forward to insightful discussions & collaborations. Thanks to the organizers! #GlobalHealth #Innovation
1
4
5
Excited for this incredible event on microfluidics & diagnostics! Great focus on Open Hardware, Sustainability & Frugal Dx—key for impactful healthcare innovation. Looking forward to insightful discussions & collaborations. Thanks to the organizers! #GlobalHealth #Innovation
0
3
7
Hi #metagenomic @nanopore community. Would anyone have spare / unused MK1C platforms available? Thank you!! 🙏🙏🙏
0
0
1
@HWUMalaysia @HeriotWattUni @HWPsych @heriotwatt_soss @tharunniaaaaaa @MushtakAlAtabi The Global Research Institute in Health and Care Technologies @HeriotWattUni is led by @ClinicalMkk and @RobertRThomson1, and you can find out more at
hw.ac.uk
Innovating health and care technologies through cutting-edge research to advance digital healthcare, improve patient outcomes, and support an ageing population.
0
4
2
In the Edinburgh region, aged 18-25 years or 60-75 years, and interested in taking part in research trying to investigate the role of fitness + inflammation in muscle ageing, then get in touch (contact details in image below). Pls RT!
0
5
6
Hi all - I've created a 🔵🦋 account - find me under the microfluidikk alias!! See you there (and still here) 👋
0
0
0
Delighted to see some @HeriotWattUni Healthcare technologies on the front page of @BBCNews this morning! Well done Vassilis Sboros and team! #HealthInnovation
0
0
2
Great platform to tap into...
Exciting news! ASLM invites you to contribute to the open-access Research Collection “Towards an Eco-Friendly Future for Microfluidics, Lab-on-a-Chip & Point-of-Care Devices” with Frontiers in Lab-on-a-Chip Technologies. Share your research, case studies & expert opinions on
0
1
5
Exciting news! ASLM invites you to contribute to the open-access Research Collection “Towards an Eco-Friendly Future for Microfluidics, Lab-on-a-Chip & Point-of-Care Devices” with Frontiers in Lab-on-a-Chip Technologies. Share your research, case studies & expert opinions on
0
1
6
After quite some time... we've finally printed our 'AirCap' finger-actuated pump on none other than our good old @formlabs Form2! (Elastic resin 50A) worked wonders! No more e-vapes needed! 😅 Might be of interest to @AyokunleOlan @ChinnaDevarapu
https://t.co/UD73GVzDj2
0
0
9
Quite a few people have asked whether they can attend the 567th inaugural lecture online. That's not typical here so we thank @CoMUIIbadan for making it possible. Note the time change - it is now 3PM on Thur 21 Nov, Trenchard Hall @UniIbadan or Youtube https://t.co/9q16NxBqxI
25
111
340
Call for Applications: Intra-Africa Fully Funded Scholarship! Looking to advance your studies and research at a different African university? Students from partner institutions and other African universities are encouraged to apply. Check eligibility and apply here:
1
63
80